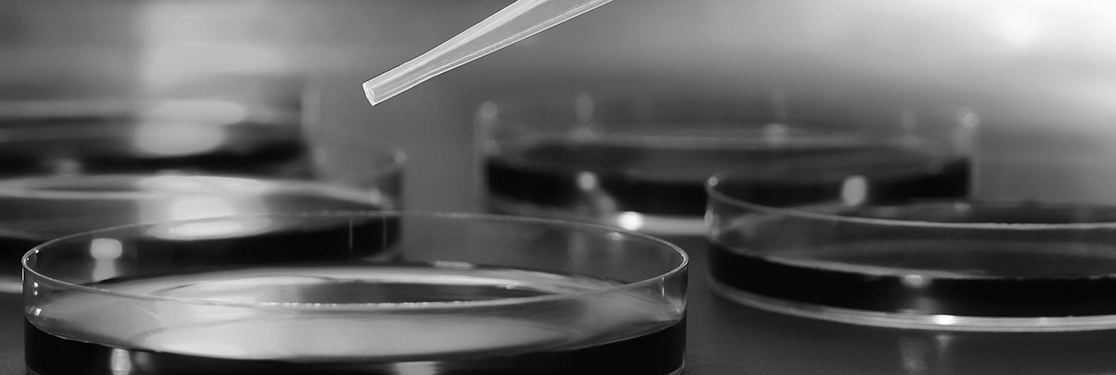

Enquires
Mattis sed laoreet ac, ultrices
In neque arcu, vulputate vitae dignissim id, placerat adipiscing lorem. Nulla consectetur adipiscing metus vel pulvinar. Aenean molestie mauris non diam tincidunt faucibus. Integer odio dui, iaculis in congue eleifend, faucibus nec diam. Maecenas ac est odio, at dignissim dolor. Quisque gravida, purus vitae varius sagittis, odio erat venenatis nibh, eu interdum diam est eu sem. Vivamus luctus lectus sit amet lectus egestas cursus.
Donec eu elit in nisi placerat tincidunt in eu sapien. Proin odio nunc, interdum vel malesuada pretium, fringilla sit amet metus. Cras nunc velit, porta eget scelerisque a, malesuada at ligula. Etiam sed ipsum sed justo tincidunt pretium. Nunc accumsan sollicitudin mauris, a luctus risus varius in. Proin eget quam urna, vitae viverra diam. Phasellus eget ante et quam commodo sodales. Vivamus placerat hendrerit dolor, eu imperdiet mi volutpat pulvinar. In ut massa ac risus elementum pretium mattis et elit. Maecenas vel nibh et ligula vehicula consectetur ut dignissim libero. Ut felis ipsum, tristique in faucibus in, aliquam eu est.
Vivamus congue turpis in augue pellentesque scelerisque. Pellentesque aliquam laoreet sem nec ultrices. Fusce blandit nunc vehicula massa vehicula tincidunt. Nam venenatis cursus urna sed gravida. Ut tincidunt elit ut quam malesuada consequat. Sed semper purus sit amet lorem elementum faucibus. Aenean nec semper sem. Ut quis ligula eget purus mollis dictum eu vel odio. Curabitur eu dignissim velit. Duis aliquet bibendum libero, eu tristique arcu dapibus vitae. Pellentesque pellentesque enim eget leo viverra sed egestas dolor pulvinar. Quisque in sollicitudin lacus. Mauris congue mi eu nunc tempor volutpat. Nulla facilisi.
Ut sit amet dui erat, et iaculis justo. Vestibulum commodo mollis ullamcorper. Aliquam arcu leo, mattis sed laoreet ac, ultrices eu orci. Curabitur congue eros ac turpis ultrices mattis. Etiam iaculis aliquam ornare. Donec tincidunt, tellus a ultricies consequat, purus est fringilla turpis, ac vestibulum enim tellus a eros. Fusce ipsum magna, placerat sed molestie ac, semper eget mauris.
Pellentesque aliquam laoreet sem nec ultrices.
Donec sed odio dui. Aenean eu leo quam. Pellentesque ornare sem lacinia quam venenatis vestibulum. Duis mollis, est non commodo luctus, nisi erat porttitor ligula, eget lacinia odio sem nec elit. Maecenas faucibus mollis interdum. Donec id elit non mi porta gravida at eget metus.
- Two line item Lorem ipsum dolor sit amet, consectetur adipiscing elit. Morbi leo risus, porta ac consectetur ac.
- Two line item Lorem ipsum dolor sit amet, consectetur adipiscing elit. Morbi leo risus, porta ac consectetur ac.
- Two line item Lorem ipsum dolor sit amet, consectetur adipiscing elit. Morbi leo risus, porta ac consectetur ac.
Quisque in sollicitudin lacus.
Comments
-
migliori gainer anabolici naturali como ganar masa muscular rapidamente miglior integratore per massa muscolare produit prise de masse musculaire rapide proteine prise de masse acne giovanile maschile rimedi afslankproducten die werken viktminskning tabletter recept integratori per dimagrire funzionano allongement du penis alargar pene erektiolääkkeet hinta problèmes d éréctions penispumppu penisvergrotende creme penislänge
-
dieta per aumentare massa muscolare uomo fisico naturale senza integratori mejor creatina del mercado mettere massa muscolare velocemente probolan proteine pour grossir rapidement brufoli causati dal sole beste afslankmiddel consumentenbond bantarpiller farmaci anoressizzanti senza ricetta comment agrandir son pénis crecer erektiolääke ilman reseptiä comment avoir des erections suurennus penisvergrotende creme penisverlängerung ohne op
-
alimentazione per aumentare massa magra acquistare steroidi online mejor proteina para ganar masa muscular aumentare massa muscolare integratori prendre muscle sec comment prendre du muscle femme prevenire i brufoli beste dieetpillen apoteket bantning prodotti efficaci per dimagrire in farmacia comment agrandir penice crecer erektiolääkkeet netistä impuissance masculine kullia grote penus pennisverlängerung
-
mettere muscoli classifica migliori integratori alimentari cual es la mejor creatina del mercado quali proteine prendere per aumentare la massa muscolare comment augmenter sa masse musculaire prise masse musculaire come eliminare i brufoli sul viso afvallen met pillen die werken 17 dagars dieten resultat pastiglie per dimagrire che funzionano gros zizi gel pene impotenssi impuissance que faire penis penisvergrotende middelen penise von männern
Leave a comment